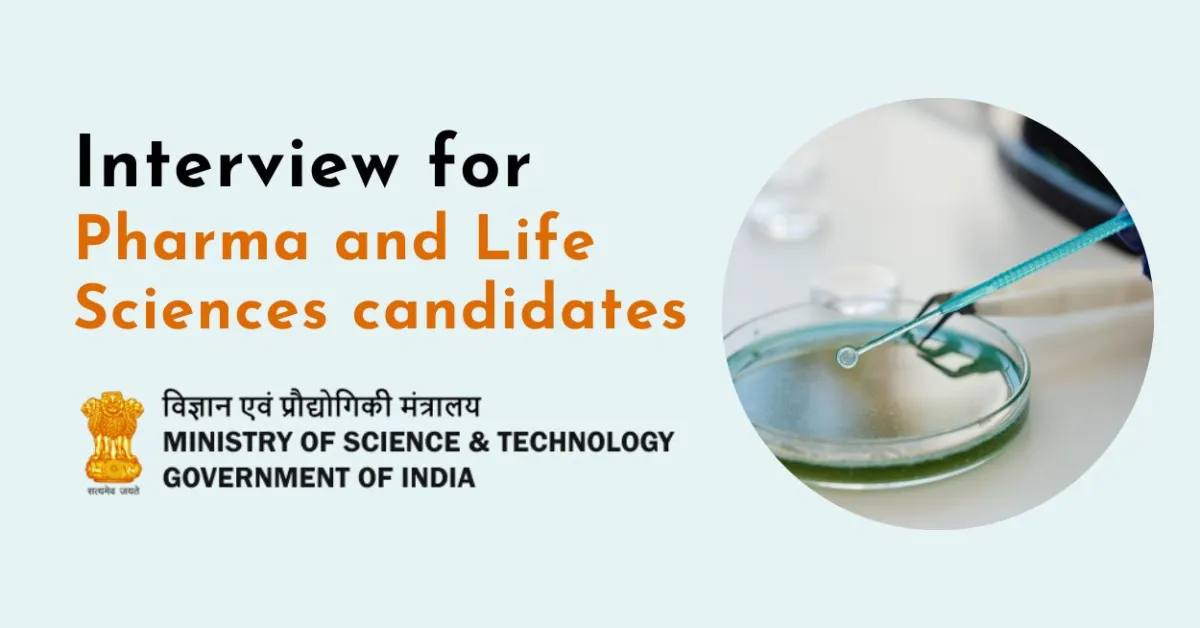
Interview for Pharma and Life Sciences candidates under Ministry of Science & Technology

BRIC-Translational Health Science and Technology Institute (THSTI) is an Institute of the Biotechnology Research and Innovation Council, Department of Biotechnology, Ministry of Science & Technology, Govt. of India. The institute conducts innovative translational research and to develop research collaborations across disciplines and professions to translate concepts into products to improve human health.
Rolling Recruitment Notice No.: THS/RN/01/2026/04-I
Project Associate- II (One post)
Project : Expansion of INSACOG–Wastewater Surveillance of SARS-CoV-2, Emerging Pathogens, and Antimicrobial Resistance through Genomics-Based Methods
PI : Dr. Bhabatosh Das
Age Limit : 35 years
Essential Qualification and Experience : M.Tech./ M.Pharm. or Master’s degree in any branch of Life Sciences from a recognized university with at least two(2) years of post-qualification research experience.
Job Description : Candidates should have a strong background in multi-omics, or microbiology, or environmental biology with demonstrated hands-on experience in microbial culture and/or the collection and processing of environmental samples.
Monthly Emoluments : i) Rs. 35,000/- +HRA Scholars who are selected through (a) National Eligibility Tests – CSIR – UGC NET including lectureship or GATE or (b) A selection process through National level examinations conducted by Central Department and their agencies and institutions) ii) Rs. 28,000/- + HRA for others who do not fall under (i) above.
Date for walk-in interview- 12th May 2026
* The applicants who wish to appear in the Interview virtually shall submit request to the PI via email having subject line as - ‘Request for online Interview for the post of Project Associate- II’ along with the scanned copy of their relevant educational qualification & experience documents and the applicant should satisfy themselves that they possess the minimum eligibility criteria as laid down for the said post on or before 7th May 2026. The request received after the due date and without submission of the documents shall not be considered for virtual Interview under any circumstances.
Senior Project Associate (One post)
Project : BRIC- Bio Foundry- A Bio Enabler at the NCR Bio Cluster for Promoting Bio Manufacturing of High-Quality Bio-Innovation Leads
PI : Dr. Bhabatosh Das
Age Limit : 40 years
Essential Qualification and Experience : Master’s degree in any branch of Life Sciences from a recognized university with atleast four (4) years’ of post- qualification experience in Microbiology.
Job Description : The selected candidate will be responsible for Microbial genetics, Small- and medium-scale culture optimization of aerobic and anaerobic bacteria and animal studies .
Monthly Emoluments : Rs. 42,000/- plus HRA
Date for walk-in interview- 12th May 2026
Principal Project Associate (Three posts)
Project : BRIC- Bio Foundry- A Bio Enabler at the NCR Bio Cluster for Promoting Bio Manufacturing of High-Quality Bio-Innovation Leads
PI : Dr. Bhabatosh Das
Age Limit : 40 years
Essential Qualification and Experience : Master’s degree in any branch of Life Sciences from a recognized university with atleast eight (8) years’ of post- qualification experience in the field of Microbiology. OR Ph.D. in any branch of Life Sciences or equivalent degree from a recognized university, with atleast four (4) years’ of post- qualification experience in the field of Microbiology.
Job Description : The selected candidate will be responsible for Microbial genetics, Small and medium-scale culture optimization of aerobic and anaerobic bacteria and animal studies for toxicity assays of selected bacterial taxa .
Monthly Emoluments : Rs. 49,000/- plus HRA
Date for walk-in interview- 12th May 2026
General Terms & Conditions
1. These are the short-term positions, and extension will be granted subject to satisfactory performance of the incumbents and tenure of the project for which they are selected. Those appointed to these positions will not have any claim for regularization of their employment.
2. All educational, professional and technical qualification should be from a recognized Board/University.
3. The experience requirement specified above shall be the experience acquired after obtaining the minimum educational qualifications specified for the post. The candidates are required to satisfy themselves, before applying /appearing for the selection process, that they possess the minimum eligibility criteria as laid down in the recruitment advertisement. No query will be entertained with regard to eligibility criteria.
4. The date of Interview of the respective post will be the CRUCIAL DATE for determining eligibility with regard to age, experience, essential qualification etc.
5. Age and other relaxations for direct recruits and departmental candidates: 1. By five years for candidates belonging to SC/ST communities. 2. By three years for candidates belonging to OBC communities. 3. For Persons with Benchmark Disabilities (PwBD) falling under the following categories : (i) UR - ten years, ii) OBC - 13 years (iii) SC/ST - 15 4. Age is relaxable for Central Government servants up to five years in accordance with the instructions or orders issued by the Central Government, from time-to-time. 5. Institute employees will get the age relaxation to the extent of the service rendered by them as on closing date of advertisement. 6. For Ex-servicemen upto the extent of service rendered in defence forces (Army, Navy & Air force) plus 3 years provided they have put in a minimum of 6 months attested service.
6. All results/notifications will only be published on our website. Therefore, the candidates should essentially visit THSTI website, regularly.
7. All communications will only be made through email.
8. In case a large number of applications are received, screening will be done to limit the number of candidates to those possessing higher/relevant qualification and experience.
9. The no. of vacancy indicated above may change subjected to the actual requirement at the time of Written test/skill test/interview.
10. With regard to any provisions not covered in this notification, the bye laws of THSTI / Govt. of India rules / guidelines shall prevail.
11. Canvassing wrong information in any form will be a disqualification.
For posts mentioned above, interested candidates fulfilling the criteria as mentioned above may walk- in for written test/skill test/interview at 9:00 am on the date mentioned against each position at THSTI, NCR Biotech Science Cluster, 3rd Milestone, Faridabad-Gurugram Expressway, Faridabad – 121001.
Note
1) The candidates must bring their latest resume, one set of photocopy of documents in support of their educational qualification and experience along with originals and a valid ID cards for verification.
2) Candidates coming after the time slot mentioned will not be entertained.
3) All the candidates coming for written test/skill test/interview are mandatorily required to deposit their mobile phone along with a valid Identity proof at the reception and the same will only be returned back on completion of the entire selection process.
See All M.Pharm Alerts B.Pharm Alerts B.Sc Alerts D.Pharm Alerts
See All Other Jobs in our Database
Subscribe to Pharmatutor Job Alerts by Email